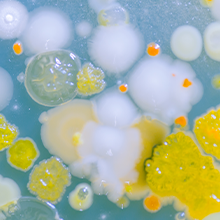
Microbial evolution 220x220.png

Abstract submission closes in one week for Understanding and Predicting Microbial Evolutionary Dynamics
23 August 2022
Abstract submission closes on Tuesday 30 August 23:59 BST for Understanding and Predicting Microbial Evolutionary Dynamics. The Focused Meeting will take place 22–23 November 2022 at Hyatt Regency Manchester, UK.
The meeting is intended to strengthen collaborative ties between researchers working in the diverse field of microbial evolution, both in the UK and overseas. It will provide opportunities for early career researchers to present their work in the form of contributed talks and poster presentations and build their collaborative networks.
Key topics include:
- Drivers and dynamics of microbial evolution
- Evolution of (pan)genomes
- Evolution of microbial communities
- Predicting microbial evolution
- Biotechnological applications of microbial evolution
For advice on what to include in your abstract, you can download our guide ‘How to write a great abstract’.
You can keep up to date with the meeting on our Twitter @MicrobioSoc using the hashtag #MicroEvo22. We will also be sharing stories on Instagram throughout the event.
Image: iStock/KuLouKu.
